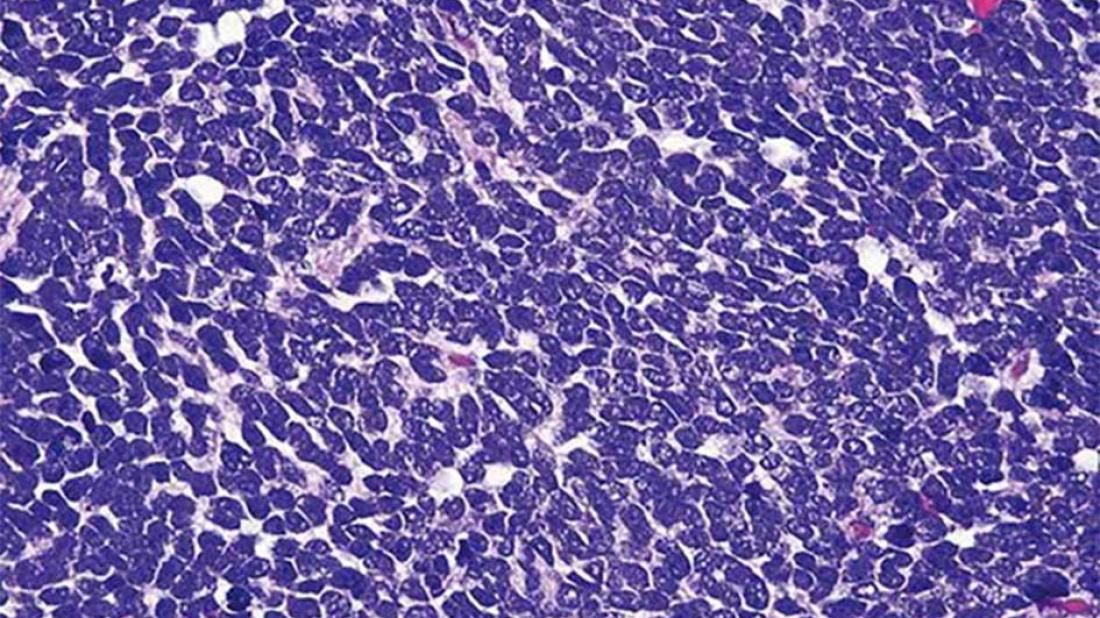

Прорыв, который принесёт пользу госпиталям по всему миру: ключевой инструмент для лечения наиболее распространённых опухолей головного мозга у детей.
Двое учёных из Исследовательского Института Сант Жоан де Деу - Синциа Лаварино (Cinzia Lavarino) и Соледад Гомес (Soledad Gómez) разработали новую методологию, которая позволяет быстро и точно определить тип медуллобластомы (самая частая опухоль головного мозга у детей). Данный способ доступен для большинства медицинских центров. До настоящего времени, онкологам приходилось отправлять образец опухоли в лаборатории в Торонто (Канада) или Гейдельберге (Германия). Это единственные лаборатории, у которых есть геномная платформа, поэтому, получение результатов лечащим онкологом, помимо высокой стоимости, занимало недели.
Чтобы разработать эту новую методологию, Соледад Гомес в течение двух лет проанализировала более 1500 образцов медуллобластом в поисках минимального количества маркеров, которое позволило бы ей идентифицировать каждую подгруппу опухоли правильным, точным и быстрым способом. Большим достижением этого открытия является то, что необходимые технологии и методологии находятся в лабораториях большинства медицинских центров, которые лечат детей с опухолями головного мозга, так что исследование проводится в том же центре и в более короткие сроки: в течение пятнадцати дней.
Определение типа медуллобластомы имеет чрезвычайно важное значение. Исследователи обнаружили, что эти опухоли головного мозга очень неоднородны и имеют различную клиническую эволюцию. Некоторые из них очень агрессивны и должны лечиться всеми доступными способами. С другой стороны, есть медуллобластомы, которые имеют более благоприятное клиническое течение и быстро реагируют на менее агрессивное лечение. Новая методология позволяет онкологам назначить каждому пациенту индивидуальное лечение и сделать это в кратчайшие сроки после постановки диагноза.



